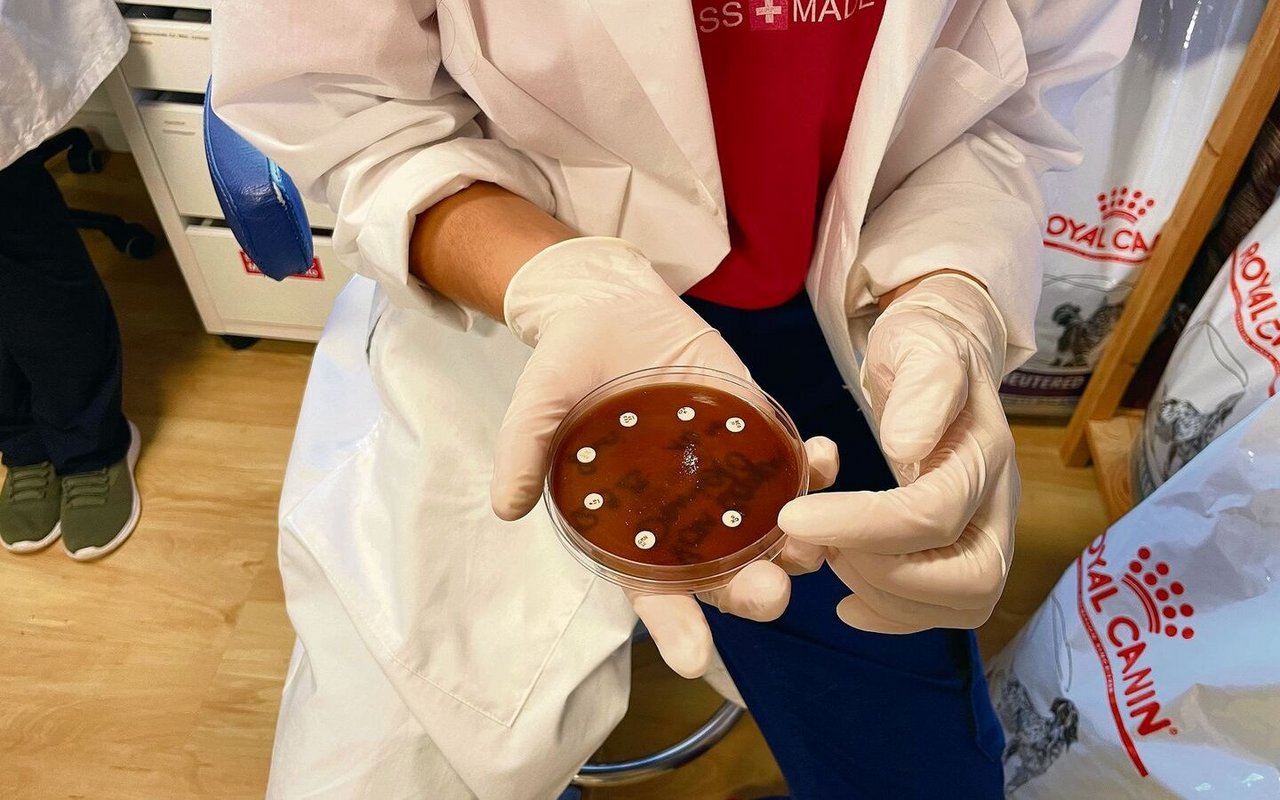
Auch Laborarbeit gehört zum Alltag einer Tierärztin. Hier wird getestet welches Antibiotikum laut einer Milchprobe am besten bei der entsprechenden Kuh einzusetzen ist.

Tierberufe
Die Doktorinnen und das widerspenstige Vieh
Viele Mädchen antworten mit «Tierärztin», werden sie nach ihrem Traumberuf gefragt. Zwischen notfallmässiger Kuhbehandlung und anspruchsvollem Katzenultraschall erfahren wir von zwei Nachwuchstierärztinnen, wie es in Realität ist, in diesem Job zu arbeiten.
Kater Max bäumt sich auf und langt mit einer Vorderpfote energisch nach Sofia Benagli. Praktikantin Eva Fankhauser gelingt es nur mit Müh und Not, die rote Katze in Schach zu halten. Von der bevorstehenden Impfung hält Max rein gar nichts. «Wir müssen uns eine andere Behandlungsmöglichkeit überlegen», sagt die junge Tierärztin mit dem sympathischen Tessiner Akzent und setzt den Kater erst einmal zurück in seine Transportbox.
Da hat sich die erste Patientin dieses Morgens, die 14-jährige Hündin Luna, umgänglicher gezeigt. Auch ihr waren die Impfung, Ohren- und Zahnkontrolle nicht ganz geheuer. Sie zitterte trotz des guten Zuredens der Tierärztin wie Espenlaub, liess die Behandlung aber ohne Widerrede über sich ergehen.
[IMG 2]
Sie würde Max gerne im Zwangskäfig sedieren, um zusätzlich zur Impfung noch eine Blutentnahme, einen Ultraschall sowie Röntgenbilder zu machen, erklärt Sofia Benagli ihrem Chef Bruno Lötscher. Denn es besteht der Verdacht auf ein Nieren- oder Schilddrüsenproblem beim 13-jährigen Kater. Dies hält der Leiter der gemischten Tierarztpraxis in Brienz (BE) für einen guten Plan. «Unser oberstes Ziel ist immer, dass sich der Tierarzt oder die Tierärztin nicht verletzt.»
Abgestürzte Kühe
Bis Max tief und fest schläft, verstreicht gut eine halbe Stunde. Sofia Benagli, die vor drei Monaten bei Bruno Lötscher ihre erste Stelle nach dem Studium angetreten hat, und Veterinärmedizinstudentin Eva Fankhauser, die mit diesem Praktikum in ihr viertes Studienjahr gestartet ist, nutzen die freien Minuten, um die Milchprobe einer Kuh zu begutachten. Die aktuell trockengestellte Kuh befindet sich auf einer Alp, die durchs geöffnete Praxisfenster auf der gegenüberliegenden Seeseite zu erspähen ist, und leidet an einer Euterentzündung. Während Bruno Lötscher mit den beiden jungen Frauen bespricht, welches Antibiotikum laut der Probe am besten einzusetzen ist, kommt er ins Erzählen. Vor wenigen Wochen hätten sie mit dem Rega-Helikopter zu einem Kalb hochgeflogen werden müssen, das sich in den schroffen Felshängen verirrt hatte. Erst nach der Betäubung mit dem Blasrohr konnten die Tierärzte das halbwilde Jungtier an der Transportvorrichtung fixieren und zu seiner Mutter fliegen. Eine Kuh sei vor Kurzem im steilen Gelände ausgerutscht und abgestürzt, was auf der Alp nicht selten vorkommt und tödlich enden kann. Bei der Lieblingskuh ihres Besitzers lag «nur» ein Beinbruch vor. Dieser wurde fixiert, die Kuh wurde mit dem Helikopter ins Tal geflogen und von dort aus mit dem Viehtransporter ins Tierspital nach Bern gebracht. Der Beinbruch war aber so kompliziert, dass nichts anderes übrigblieb, als das tapfere Tier zu erlösen. «Mein extremster Einsatz war bei drei in eine tiefe Gletscherspalte gestürzten Rindern», so Bruno Lötscher. Von der Höhlenrettung sei er damals abgeseilt worden. Tief im Eis unten zeigte sich die Situation dermassen ausweglos, dass leider keine andere Option übrig blieb, als alle drei Tiere zu euthanasieren.
[IMG 3]
Endlich ist Max eingeschlummert und das Dreierteam kann sich an die Untersuchungen machen. Die junge Tessinerin, die noch vor wenigen Monaten mit ihren Eseln quer durch die ganze Schweiz marschierte, beginnt mit dem Ultraschallgerät den Bauchraum der Katze abzutasten. Die Blase ist schnell gefunden, bei der Niere wird es schwieriger. Bruno Lötscher steht mit Rat und Tat zu Seite. «Ich finde es schön und wichtig, junge Tierärztinnen beim Berufseinstieg zu begleiten.» Als Gegenleistung fliesse so das neuste Wissen aus den Universitäten in seine Praxis ein.
«Bei uns machen alle alles, Klein- wie Grosstiere behandeln und Administratives.»
Während das Dreierteam die Organe der Katze begutachtet, klingelt immer wieder das Telefon. Eine Ziegenhalterin fragt nach den Wurmproben, ein Schildkrötenbesitzer möchte einen Termin, um den krumm gewachsenen Schnabel zu kürzen. Die Tiermedizinische Praxisassistentin ist nur zu 40 Prozent angestellt. «Bei uns machen alle alles, Klein- wie auch Grosstiere behandeln, Administratives abarbeiten, aber auch mal den Putzlappen in die Hand nehmen», erklärt Bruno Lötscher mit einem sympathisch-schalkhaften Lächeln.
Die Tücken des Ultraschallgerätes
Als das Telefon bestimmt schon zum sechsten Mal an diesem Morgen klingelt, geht es nicht bloss um eine Kleinigkeit. Die Kuh eines Bauern aus der Umgebung ist in einem schlechten Zustand und braucht notfallmässig die Hilfe der Tierärzte. Während Sofia Benagli allein mit der Untersuchung von Max weiterfährt, schnappen sich Eva Fankhauser und Bruno Lötscher alle notwendigen Utensilien, springen ins Auto und düsen los. Laut der Schilderung des Besitzers könnte es sich um eine Lungenentzündung oder um einen aufgefressenen Fremdkörper handeln, also um eine ernst zu nehmende Sache. Sie bekämen zu jeder erdenklichen Tages- und Nachtzeit auch Anrufe zu teils skurrilen Problemen. Vom Elch, der über den See schwimme, bis zur Giftschlange, die aus dem Garten entfernt werden müsse, sei schon so ziemlich alles dabei gewesen, schmunzelt der erfahrene Tierarzt. «Als Landpraxis sind wir für alle Tierfragen die erste Anlaufstelle und leisten einen Beitrag zum Service Public.»
[IMG 4]
Die vierjährige, trächtige Tamina gibt ein jämmerliches Bild ab. Die Milchkuh hat stark Fieber, frisst nicht mehr und leidet unter Durchfall. Eva Fankhauser hat sich einen Untersuchungsmantel umgelegt, misst die Temperatur und hört die Lunge ab. 41 Grad Celsius und ein Rasseln auf der Lunge deuten tatsächlich auf eine Lungenentzündung oder Zeckenfieber hin. Nun kommt der schwierige Teil: Mit dem Ultraschall muss überprüft werden, ob das Kalb in einem normalen Entwicklungsstadium ist. Gelingen will dies noch nicht reibungslos. Der Arm der jungen Frau mit dem lockigen Pferdeschwanz steckt bis zur Achselhöhle in der Kuh, in der Hand hält sie den Ultraschallsensor. Doch eine Abbildung des Kuhinneren will sich partout nicht auf dem Monitor zeigen und zu allem Übel macht sich der Durchfall just in diesem Moment besonders gut bemerkbar. Auch hier gibt Bruno Lötscher seelenruhig Anweisungen. «Das ist wichtiges Learning by Doing, unser ganzes Studium ist sehr theoretisch ausgelegt», sagt Praktikantin Eva Fankhauser, die bei der zweiten Kuhuntersuchung ihres Lebens ganz schön ins Schwitzen kommt. Der erfahrene Tierarzt übernimmt es anschliessend, die Antibiotikaspritze anzusetzen und ein Pulver, das den Pansen wieder ins Lot bringen soll, einzuflössen. Mit etwas gutem Heu zum Kauen sollte es Tamina bald wieder besser gehen, versichert er zum Abschied dem jungen Landwirt.
[IMG 5]
Früher hätten solche Einsätze bei Nutztieren etwa 75 Prozent der Arbeit in seiner Landpraxis ausgemacht und die Kleintieruntersuchungen nur 25 Prozent. Dies habe sich mittlerweile stark zu Gunsten der Kleintiere verschoben, so Lötscher. Neuerdings müssen sich die angehenden Tierärzte bereits im Studium für die Schwerpunktrichtung Klein- oder Grosstiermedizin entscheiden.
Wurmeier und Work-Life-Balance
Zurück in der Praxis stehen Laboruntersuchungen an. Der Mist von Tamina sowie der Kot eines Hundes müssen auf Wurmeier untersucht werden. Sofia Benagli erklärt Eva Fankhauser Schritt für Schritt, wie eine sogenannte Flotation angesetzt wird. Beide kämpfen damit, den Würgereiz zu unterdrücken – es gibt sicherlich erfreulichere Aufgaben zu erledigen.
«Das ist wichtiges Learning by Doing, unser Studium ist theoretisch.»
Ein Trost, dass es nach der Wurmeisuche bereits Zeit für das Mittagessen ist. Dazu verlassen die drei die Praxis und setzen sich bei einem Risotto zusammen. «Es ist wichtig, auch einmal einen Cut zu machen und über etwas anderes als kranke Tiere miteinander zu reden», so Bruno Lötscher. Überhaupt ist dem Praxisinhaber die Work-Life-Balance seiner Mitarbeiterinnen wichtig. Dafür hat er ein Zeiterfassungssystem entwickelt, das beispielsweise nächtliche Notfalleinsätze speziell vergütet. Den Tierärztinnen ist es möglich, die Überzeit zu kompensieren. Einmal im Monat habe jede das Anrecht auf ein verlängertes Wochenende. So möchte der engagierte Tierarzt dazu beitragen, dass die Veterinärmediziner zwei Jahre später noch im klinisch-praktischen Bereich tätig sind. Nach dieser Zeitspanne haben rund die Hälfte der Studienabgängerinnen aufgrund der hohen Belastung entweder in die Forschung oder in die Lebensmittelsicherheit gewechselt. Oder den Beruf sogar ganz an den Nagel gehängt.
Wie wird man Tierärztin?
Nach der Maturität muss der Numerus clausus bestanden werden, um einen Studienplatz an der Vetsuisse Fakultät der Uni Bern oder Zürich zu erhalten.
Die Studiensprache ist Deutsch, Prüfungen können auf Deutsch oder Französisch abgelegt werden.
Das Studium dauert elf Semester.
Der Studiengang ist sehr anspruchsvoll und selektiv: Nach dem ersten Studienjahr scheiden nochmals fast die Hälfte der Studierenden aus.
Nach dem Grundstudium kann eine der folgenden fünf Schwerpunktrichtungen gewählt werden: Kleintiermedizin, Nutztiermedizin, Pferdemedizin, Pathobiologie, Veterinary Public Health und Biomedizinische Forschung.
Es ist wichtig, bereits während des Studiums praktische Erfahrungen in einer Tierarztpraxis oder -klinik zu sammeln.

Bitte loggen Sie sich ein, um die Kommentarfunktion zu nutzen.
Falls Sie noch kein Agrarmedien-Login besitzen:
Jetzt registrieren